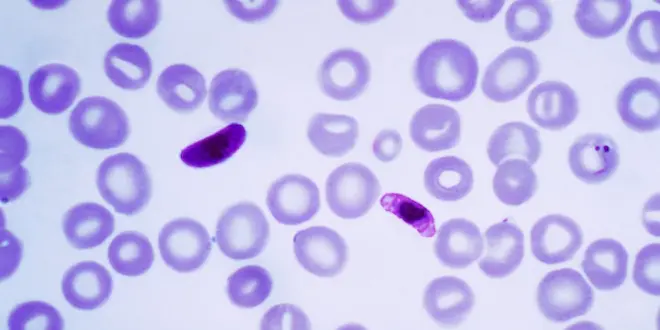

Un parasite responsable du paludisme pour traiter certains cancers ?
EN BREF – Une molécule produite par l'un des parasites responsables du paludisme possède également une grande affinité avec les cellules cancéreuses. Dans des expériences réalisées sur des souris, des chercheurs nord-américains ont utilisé cette propriété pour acheminer des substances toxiques au coeur de tumeurs. Une stratégie qui, selon les données publiées ce 12 octobre dans la revue Cell Cancer, aurait permis de guérir plusieurs animaux.
Par La rédaction d'Allo Docteurs
Rédigé le
Durant des décennies, les spécialistes des maladies infectieuses cherchaient à comprendre pourquoi Plasmodium falciparum (l'un des parasites responsables du paludisme) infectait avec beaucoup de facilité les femmes enceintes. Entre la fin des années 1990 et le début des années 2010, plusieurs travaux ont révélé que les globules rouges infectés par Plasmodium falciparum adhéraient à une protéine (la chondroïtine sulfate A, ou CSA) située à l'extrémité de structures présentes en très grand nombre à la surface des cellules du placenta.
Des chercheurs ont observé que la sur-représentation de cette CSA n'était pas l’apanage des cellules du placenta, une protéine analogue proliférant sur un autre type de cellules : celles constituant les tumeurs cancéreuses.
L'idée a donc germé d'associer la protéine "adhérente" générée par Plasmodium falciparum à des substances cytotoxiques (qui engendrent la mort cellulaire), et d'injecter ce composé dans des cultures de cellules tumorales. Au cours de ces expériences in vitro, les chercheurs rapportent que 95% des cellules cancéreuses ont été détruites.
Ce "médicament" a par la suite été testé sur des souris sur lesquelles ont été implantés trois types de tumeurs humaines : le lymphome non hodgkinien, le cancer de la prostate, et le cancer du sein métastatique.
"Pour le lymphome non hodgkinien, les tumeurs des souris traitées ont atteint le quart de la taille des tumeurs du groupe témoin", expliquent les chercheurs dans un communiqué. "Pour le cancer de la prostate, les tumeurs ont complètement disparu chez deux des six souris traitées, un mois après avoir reçu la première dose. Quant au cancer du sein métastatique, cinq des six souris traitées ont été guéries de la maladie. Les souris ne montraient aucun des effets secondaires indésirables, et leurs organes ont été indemnes [à l'issue de] la thérapie".
Si ces expériences parviennent à être reproduites par d'autres équipes, la dangereuse protéine produite par Plasmodium falciparum pourrait un jour devenir l'alliée des cancérologues, en véhiculant des traitements au coeur des cancers humains.
Source : Targeting Human Cancer by a Glycosaminoglycan Binding Malaria Protein. A. Salanti et al. Cancer Cell, 12 oct. 2015. doi:10.1016/j.ccell.2015.09.003










